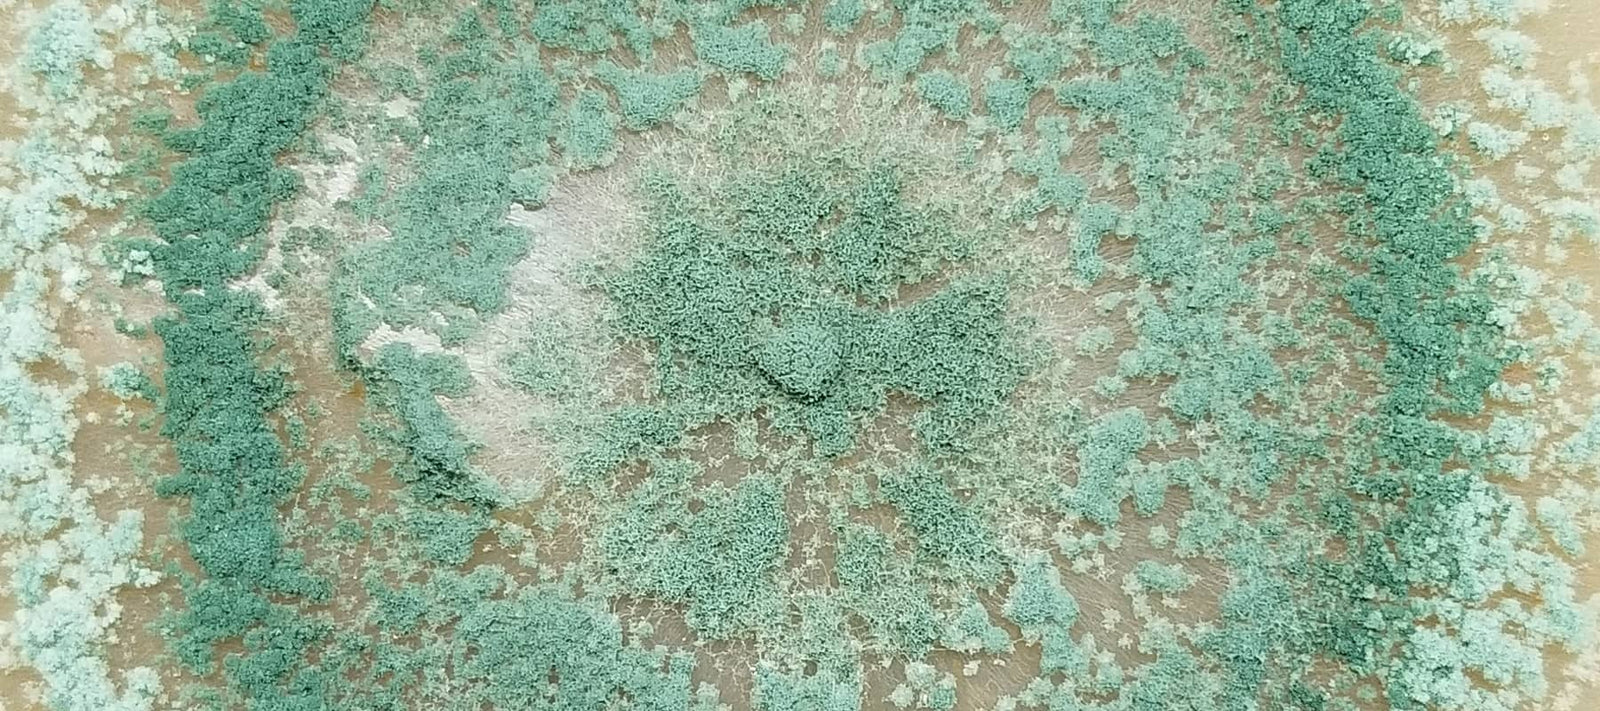
Trichoderma Hongo Entomopatógeno y Benéfico: Beneficios y Usos en la Agricultura Regenerativa

Los ácidos húmicos, los componentes principales de las sustancias húmicas, son el resultado de la descomposición de la materia orgánica, principalmente materiales vegetales. Son de color marrón oscuro a negro por naturaleza y se encuentran en el suelo, la turba, el carbón y muchos arroyos de tierras altas, lagos distróficos y agua de océano. Desempeñan un papel crucial en la salud y la fertilidad del suelo, lo que los convierte en un componente clave en las prácticas de agricultura regenerativa. Este artículo explora los beneficios y usos de los ácidos húmicos en la agricultura regenerativa, arrojando luz sobre cómo contribuyen a las prácticas agrícolas sostenibles y la conservación del medio ambiente.
Sigue el enlace para comprar nuestra marca Ácidos Húmicos solubles Sangre de Bosque®.
Entendiendo los ácidos húmicos
Los ácidos húmicos son moléculas complejas que varían ampliamente en su estructura y composición. Se forman mediante la humificación química y biológica de la materia vegetal y animal y mediante la actividad biológica de los microorganismos. Los ácidos húmicos mejoran las propiedades físicas, químicas y biológicas del suelo, contribuyendo a su fertilidad y salud generales.
Beneficios de los ácidos húmicos en la agricultura regenerativa
Mejora de la estructura del suelo
Uno de los principales beneficios de los ácidos húmicos es su capacidad para mejorar la estructura del suelo. Promueven la formación de estructura de migas en el suelo, lo que mejora la aireación del suelo, la retención de agua y la penetración de las raíces. La mejora de la estructura del suelo también reduce la erosión y la compactación, lo que hace que el suelo sea más resistente a las tensiones ambientales.
Mejora de la disponibilidad de nutrientes
Los ácidos húmicos desempeñan un papel importante en el ciclo y la disponibilidad de nutrientes. Tienen la capacidad de quelar o unir nutrientes en el suelo, haciéndolos más accesibles para las plantas. Este proceso de quelación evita que los nutrientes se filtren del suelo y garantiza que las plantas tengan un suministro constante de minerales esenciales. Al mejorar la disponibilidad de nutrientes, los ácidos húmicos pueden mejorar el crecimiento, el rendimiento y la calidad nutricional de las plantas.
Retención de agua y resistencia a la sequía
A través de su impacto en la estructura del suelo, los ácidos húmicos mejoran la capacidad de retención de agua del suelo. Esta mayor retención de agua es particularmente beneficiosa en las regiones áridas y semiáridas, donde la escasez de agua es un desafío importante. Las plantas en suelos ricos en ácidos húmicos exhiben una mejor resistencia a la sequía, ya que el suelo proporciona un suministro de humedad más constante a la zona de las raíces.
Estimulación de la actividad microbiana.
Los ácidos húmicos sirven como fuente de alimento para los microorganismos del suelo, estimulando su actividad y el crecimiento de la población. Esta actividad microbiana mejorada contribuye a la descomposición de la materia orgánica del suelo, liberando aún más nutrientes y mejorando la estructura del suelo. Una población microbiana saludable es esencial para la salud del suelo, ya que respalda diversas funciones del suelo, incluido el ciclo de nutrientes, la supresión de enfermedades y la descomposición de la materia orgánica.
Crecimiento y desarrollo de raíces mejorados
Se ha demostrado que la aplicación de ácidos húmicos estimula el crecimiento y desarrollo de las raíces. Probablemente esto se deba a su impacto en la estructura del suelo y la disponibilidad de nutrientes, así como a efectos directos en la fisiología de las plantas. Los sistemas de raíces mejorados permiten que las plantas accedan a un mayor volumen de suelo, mejorando su absorción de nutrientes y agua y su resistencia general al estrés.
Sostenibilidad del medio ambiente
El uso de ácidos húmicos en la agricultura respalda la sostenibilidad ambiental al reducir la necesidad de fertilizantes y pesticidas químicos. Al mejorar la salud del suelo y la resiliencia de las plantas, los ácidos húmicos pueden reducir los requisitos de insumos, minimizando el impacto ambiental de las prácticas agrícolas. Esto se alinea con los principios de la agricultura regenerativa, que busca restaurar y mejorar los sistemas naturales en lugar de agotarlos.
Usos de los ácidos húmicos en la agricultura regenerativa
Enmienda del suelo
Los ácidos húmicos se aplican comúnmente al suelo como enmienda para mejorar sus propiedades físicas, químicas y biológicas. Pueden aplicarse directamente al suelo o incorporarse al abono u otras enmiendas orgánicas para mejorar sus efectos beneficiosos.
Aplicación foliar
Además de la aplicación al suelo, los ácidos húmicos se pueden aplicar directamente al follaje de las plantas. La aplicación foliar puede proporcionar un rápido impulso de nutrientes y estimular respuestas fisiológicas en las plantas, lo que lleva a un mejor crecimiento y resistencia al estrés.
Tratamiento de semillas
El tratamiento de las semillas con ácidos húmicos antes de plantarlas puede mejorar las tasas de germinación y el vigor de las plántulas. Este impulso temprano puede conducir a plantas más sanas y más capaces de soportar el estrés ambiental.
Manejo integrado de plagas
Los ácidos húmicos pueden desempeñar un papel en las estrategias de manejo integrado de plagas (MIP) al mejorar la salud y la resiliencia de las plantas. Las plantas sanas son más capaces de resistir plagas y enfermedades, lo que reduce la necesidad de medidas de control químico.
Los ácidos húmicos son excelente para la agricultura regenerativa
Los ácidos húmicos ofrecen una amplia gama de beneficios para la agricultura regenerativa, desde mejorar la estructura del suelo y la disponibilidad de nutrientes hasta mejorar el crecimiento de las plantas y la sostenibilidad ambiental. Su uso en enmiendas del suelo, aplicaciones foliares, tratamientos de semillas y estrategias de manejo integrado de plagas respalda los principios de la regeneración.